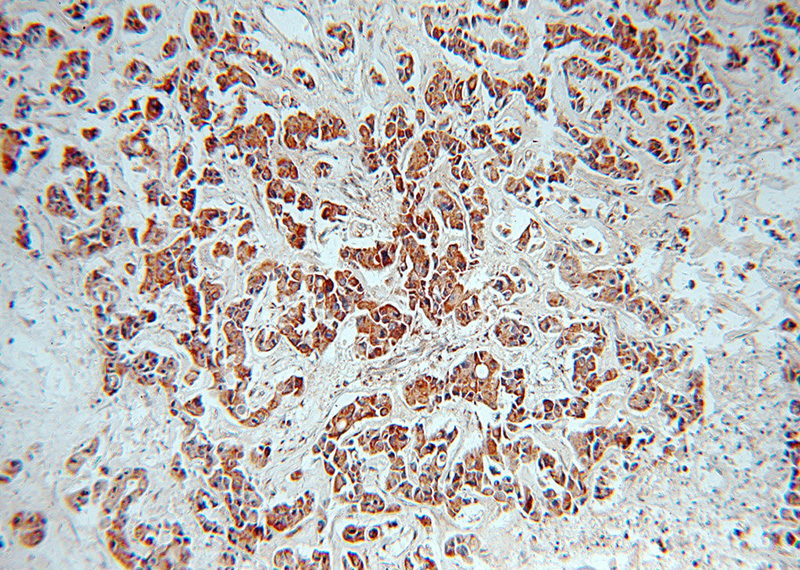
Immunohistochemical of paraffin-embedded human breast cancer using Catalog No:116020(TGFB2-Specific antibody) at dilution of 1:100 (under 10x lens)

-
Product Name
TGF-beta 2-Specific antibody
- Documents
-
Description
TGF-beta 2-Specific Rabbit Polyclonal antibody. Positive WB detected in A549 cells, K-562 cells, rat brain tissue. Positive IF detected in HeLa cells. Positive IHC detected in human breast cancer tissue. Observed molecular weight by Western-blot: 48 kDa
-
Tested applications
ELISA, WB, IHC, IF
-
Species reactivity
Human,Mouse,Rat; other species not tested.
-
Alternative names
BSC 1 cell growth inhibitor antibody; Cetermin antibody; G TSF antibody; Polyergin antibody; TGF beta 2 antibody; TGF beta2 antibody; TGFB2 antibody; TGF-beta 2 antibody
-
Isotype
Rabbit IgG
-
Preparation
This antibody was obtained by immunization of Peptide (Accession Number: NM_003238). Purification method: Antigen affinity purified.
-
Clonality
Polyclonal
-
Formulation
PBS with 0.02% sodium azide and 50% glycerol pH 7.3.
-
Storage instructions
Store at -20℃. DO NOT ALIQUOT
-
Applications
Recommended Dilution:
WB: 1:200-1:2000
IHC: 1:20-1:200
IF: 1:20-1:200
-
Validations

A549 cells were subjected to SDS PAGE followed by western blot with Catalog No:116020(TGFB2-Specific antibody) at dilution of 1:600
Immunohistochemical of paraffin-embedded human breast cancer using Catalog No:116020(TGFB2-Specific antibody) at dilution of 1:100 (under 10x lens)

Immunohistochemical of paraffin-embedded human breast cancer using Catalog No:116020(TGFB2-Specific antibody) at dilution of 1:100 (under 40x lens)

Immunofluorescent analysis of HeLa cells using Catalog No:116020(TGFB2-Specific Antibody) at dilution of 1:50 and Alexa Fluor 488-congugated AffiniPure Goat Anti-Rabbit IgG(H+L)
-
Background
Tranforming growth factor beta-2 (TGFB2), also named G-TSF, BSC-1 cell growth inhibitor, Polyergin and Cetermin, belongs to the TGF-beta family. TGFB2 is a secreted protein and contains a 19aa signal peptides at its N-terminal. Heterodimers with TGFB1 and with TGFB2 have been found in bone. It was proved to have suppressive effects on interleukin-2 dependent T-cell growth. This antibody is TGFB2 specific not detecting other TGFBs.
-
References
- Sun X, He Y, Ma TT, Huang C, Zhang L, Li J. Participation of miR-200a in TGF-β1-mediated hepatic stellate cell activation. Molecular and cellular biochemistry. 388(1-2):11-23. 2014.
- Das R, Timur UT, Edip S. TGF-β2 is involved in the preservation of the chondrocyte phenotype under hypoxic conditions. Annals of anatomy = Anatomischer Anzeiger : official organ of the Anatomische Gesellschaft. 198:1-10. 2015.
- Liu D, Li L, Zhang XX. SIX1 promotes tumor lymphangiogenesis by coordinating TGFβ signals that increase expression of VEGF-C. Cancer research. 74(19):5597-607. 2014.
Related Products / Services
Please note: All products are "FOR RESEARCH USE ONLY AND ARE NOT INTENDED FOR DIAGNOSTIC OR THERAPEUTIC USE"
